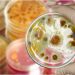
Hongos patógenos están adaptándose a temperaturas más altas

Hay un sospechoso detenido.
Mission, Texas.- Un hombre murió baleado el lunes por la noche en Mission, según informó la policía de esa ciudad.
Las autoridades acudieron a un llamado sobre un posible tiroteo a las 8:36 p.m. en la cuadra 2800 de Dinastía Dorado St.
Según se informó, un tiroteo terminó con un hombre muerto. Las autoridades indicaron que detuvieron a un sospechoso para interrogarlo.